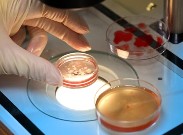

Dr. Zekai Tahir Burak Kadın Doğum Hastanesi'nde bir ayda 49 bebeğin hayatını kaybetmesinin ardından harekete geçen Sağlık Bakanlığı'nın tüp bebek merkezlerine yenidoğan ünitesi kurulması şartı getirmeye hazırlanması, tartışmaları da beraberinde getirdi.
Dr. Zekai Tahir Burak Kadın Doğum Hastanesi'nde bir ayda 49 bebeğin hayatını kaybetmesinin ardından harekete geçen Sağlık Bakanlığı'nın tüp bebek merkezlerine yenidoğan ünitesi kurulması şartı getirmeye hazırlanması, tartışmaları da beraberinde getirdi.
Asıl işlerinin gebeliği sağlamak olduğunu belirten tüp bebek merkezleri, "Bebek sahibi olmak isteyenlerin büyük çoğunluğu başka illerden geliyor ve gebe kaldıktan sonra kendi illerinde doğum yapıyorlar" diyerek, bu tür bir uygulamanın dünyanın hiçbir yerinde olmadığını savunuyorlar.
Sağlık Bakanlığı'nın yeni düzenlemesi ile 110 tüp bebek merkezi yakın takibe alınacak. Anne rahmine çok sayıda embriyo yerleştirilmesinin önüne geçilerek, embriyo transferi sayısı 3'ten 2'ye indirilecek. Tüp bebek merkezlerine ilişkin yeni kuralların getirileceği düzenlemeye göre bu merkezlere, riskli gebenin takip edilebileceği, doğumun ve gerekiyorsa bebeğin yoğun bakımının da yaptırılabileceği bir merkez olması şartı koşulacak. Ayrıca mevcut merkezlere, riskli yenidoğanların takibinin yapılabileceği bir yoğun bakım merkezi ile anlaşma yapma zorunluluğu getirilerek, tüp bebek işlemlerinin yapılabilmesine, ancak bu koşullarda müsaade edilecek.
Hasta takibi zor olur
Sağlık Bakanlığı'nın yeni düzenlemesi tüp bebek merkezlerini adeta "isyan" ettirdi. Türk Jinekoloji Derneği Başkanı Prof. Dr. Bülent Traş, düzenleme ile yeni açılacak olan tüp bebek merkezlerine yenidoğan ünitesi olmaz ya da hastane içinde bulunmazlarsa ruhsat verilmeyeceğini söyleyerek "Normalde bir yenidoğan merkezini, tüp bebek merkezlerinin açması bizim açımızdan normal bir uygulama değil" dedi. Asıl işlerinin gebeliği sağlamak olduğunu belirten Traş, gebeliğin devamı ve takibinden sorumlu olmadıklarını ifade etti. Hastalarının farklı şehirlerden geldiğini ifade eden Traş, hasta takibinin bu açıdan da zor olacağını kaydetti. Yenidoğan ünitelerinin kamu, üniversite ve özel hastanelerde olduğunu kaydeden Prof. Dr. Traş, "Bu koşullar altında tüp bebek merkezlerinin yeni doğan merkezi kurması ya da yeni doğan üniteleri bağlantılı olması anlamsız" diye konuştu.
Üreme Sağlığı ve İnfertilite Derneği Başkanı Doç. Dr. Bülent Urman tek seferde embriyo transferi sayısının 3'ten 2'ye indirilmesi yönündeki çalışmaları desteklediğini söyledi. Urman, tüp bebek merkezi içinde yoğun bakım ünitesi olmasının ise gereksiz bir uygulama olacağını savunarak "Bu merkezlerde yapılan tedavi ile gebe kalan çiftler başka illerden gelmektedir ve kendi illerinde doğum yapmaktadırlar" dedi.
Bakanla görüşecekler
Tüp Bebek Merkezleri Derneği Başkanı Doç. Dr. Ahmet Zeki Işık ise böyle bir düzenlemenin teknik olarak mümkün olmadığını savunarak "Tüp bebek merkezlerinin, yapı olarak doğum yapılan ve ardından çocuğun bakıldığı bir merkez haline gelmesi gibi bir şey söz konusu olamaz. Yapılan işlemler arasında çok büyük farklar var. Dünyanın hiçbir yerinde tüp bebek yapanlar doğum yaptırmazlar" dedi. Işık, sorunun çözümü için mümkün olduğunca az embriyo transferi yapmak gerektiğini söyledi.
Zekai Tahir Burak Hastanesi'ndeki bebek ölümlerinin hastane yoğunluğundan kaynaklandığını söyleyen Doç. Dr. Işık, "Hastane kimseyi reddedemiyor ki. 'Yerim yok' diyemiyor. Bunun kalitesini artırmak devletin işi. Bunun dışında yenidoğan ünitesi açın, orayla burayla anlaşın. Bunlar pratikte olamayacak işler" diye konuştu.
Öte yandan tüp bebek merkezleriyle ilgili yeni düzenlemelere ilişkin, Üreme Tıbbı Derneği, Üreme Sağlığı ve İnfertelite Derneği ile Özel Tüp Bebek Merkezleri Derneği'nin salı günü Sağlık Bakanı Recep Akdağ ile görüşecekleri öğrenildi.

![]()